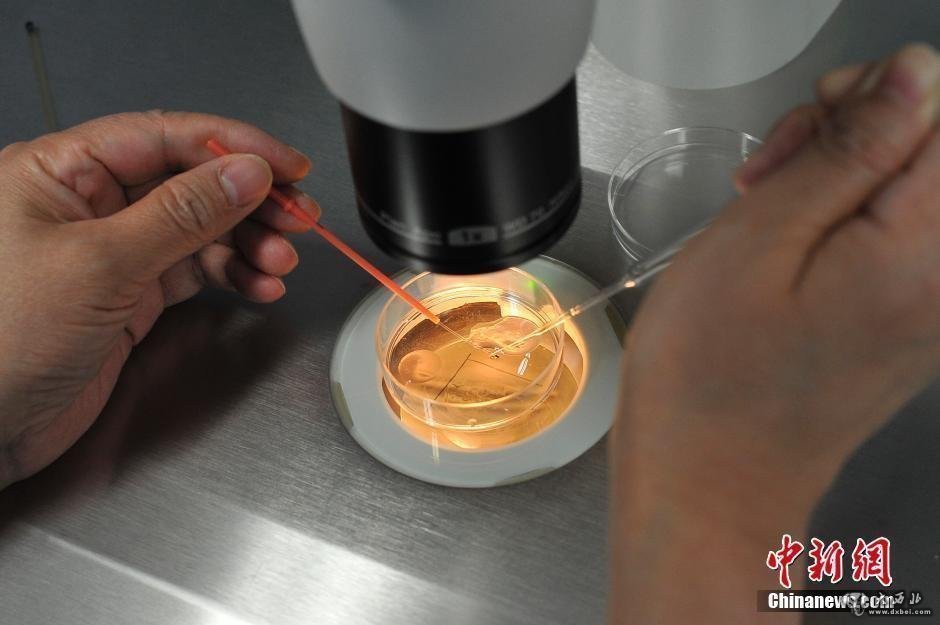

6月8日,山西省太原市,记者跟随医生探访山西省人口计生委科学研究所,观看了“试管婴儿”技术的全过程。随着二孩政策的开放,“试管婴儿”成为年纪偏大人群实现生育的一种方式。图为主刀医生张凤敏手持取卵针为待孕女性取卵。

图为医护人员收集医生取出的卵子。

图为医生将精子滴入装有卵子的培养皿中后,用显微镜监测。

图为医生将装有精子与卵子的培养皿放入培养箱,培养箱温度约37摄氏度,模拟人体宫腔环境。
图为医生将培养成功的受精卵放入红色管状容器中等待冷冻。

图为医生将受精卵放入液氮中冷冻储存。
(责任编辑:鑫报)










